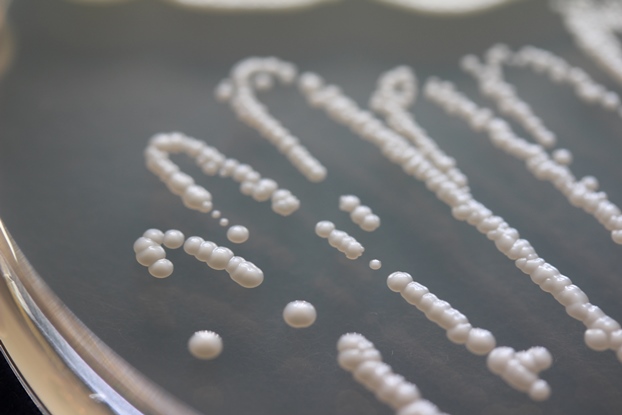
ODC-50

BIOPOT is a carrier based as well as liquid formulation containing 9
potash mobilizing bacterium . The product contains upto 1x10 cells per ml
of the product. The Microbes are benecial bacterium to the all kinds of
crops like cereals, millets, legumes; cash crops like sugarcane and cotton; vegetables, owering plants and
plantations. It mobilizes potash from soil to plants and meets the demand of third most important nutrient of
crops – potash. It is very efcient in soils of low potash and mobilizes up to 50 kg potash per hectare.
BIOPOT is a carrier based as well as liquid formulation containing 9
potash mobilizing bacterium . The product contains upto 1x10 cells per ml
of the product. The Microbes are benecial bacterium to the all kinds of
crops like cereals, millets, legumes; cash crops like sugarcane and cotton; vegetables, owering plants and
plantations. It mobilizes potash from soil to plants and meets the demand of third most important nutrient of
crops – potash. It is very efcient in soils of low potash and mobilizes up to 50 kg potash per hectare.
MODE OF ACTION :
- The cells of BIOPOT (KSB) potash mobilizing bacteria , as soon as reaches to soil either
through seed, seedling, sets or through soil application becomes active and begin multiplying. They use organic
carbon from soil or root exudates and mobilize potash from soil. This is potash made available to plants by recycling
from soil-bacteria-plant.
Application
- Soil application Mix 500 g BIOPOT powder in 100 kg well decomposed manure/ compost. Broadcast
in 1 acre land area before rst irrigation.Mix 500 ml of liquid BIOPOT in100 kg well decomposed manure/ compost.
Mix well and broadcast in 1 acre land area before rst irrigation.
ADVANTAGES
- Supply 30-40 kg/ha potash to the crops
- Save up to 25% cost on chemical fertilizers.
- Environment friendly
packing : :100ml/ 500ml in liquid and 500gm/ 1000gm in powder
BIOPOT is a carrier based as well as liquid formulation containing 9
potash mobilizing bacterium . The product contains upto 1x10 cells per ml
of the product. The Microbes are benecial bacterium to the all kinds of
crops like cereals, millets, legumes; cash crops like sugarcane and cotton; vegetables, owering plants and
plantations. It mobilizes potash from soil to plants and meets the demand of third most important nutrient of
crops – potash. It is very efcient in soils of low potash and mobilizes up to 50 kg potash per hectare.
BIOPOT is a carrier based as well as liquid formulation containing 9
potash mobilizing bacterium . The product contains upto 1x10 cells per ml
of the product. The Microbes are benecial bacterium to the all kinds of
crops like cereals, millets, legumes; cash crops like sugarcane and cotton; vegetables, owering plants and
plantations. It mobilizes potash from soil to plants and meets the demand of third most important nutrient of
crops – potash. It is very efcient in soils of low potash and mobilizes up to 50 kg potash per hectare.